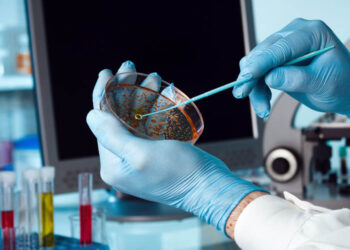

Νέος θάνατος στη Δυτικη Μακεδονία από κορονοϊο- Πρόκειται για τον 64χρονο ιδιοκτήτη του καφενείου της Δαμασκηνιάς- Νοσηλευόταν στο ΑΧΕΠΑ
Δυστυχώς συνεχίζονται οι δυσάρεστες ειδήσεις για τη Δυτική Μακεδονία, καθώς λίγο πριν έγινε γνωστό πως ένα ακόμα άνθρωπος έχασε τη ...